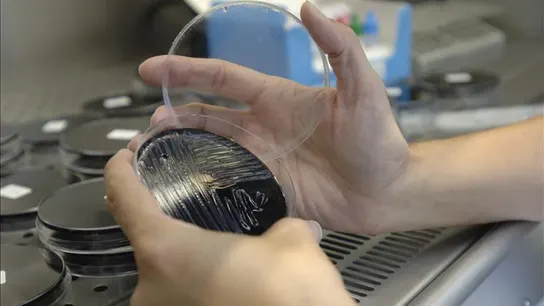
El brote de legionella de Ciudad Real afecta a 41 personas El brote de legionella de Ciudad Real afecta a 41 personas

CINCO DE LOS INGRESADOS SE ENCUENTRAN EN ESTADO GRAVE

CINCO DE LOS INGRESADOS SE ENCUENTRAN EN ESTADO GRAVE

Los afectados por legionela en Ciudad Real ascienden a 220

Los afectados por legionela en Ciudad Real ascienden a 220

SIGUEN INVESTIGANDO EL FOCO DE LA BACTERIA

SIGUEN INVESTIGANDO EL FOCO DE LA BACTERIA

AUMENTAN A 190 LOS CASOS DE LEGIONELA EN CIUDAD REAL

AUMENTAN A 190 LOS CASOS DE LEGIONELA EN CIUDAD REAL

UNA FUENTE PUEDE SER EL POSIBLE FOCO

UNA FUENTE PUEDE SER EL POSIBLE FOCO

Dos personas muertas y 109 contagiadas por el brote de legionela en Ciudad Real

Dos personas muertas y 109 contagiadas por el brote de legionela en Ciudad Real

20 PERSONAS ESTÁN HOSPITALIZADAS

20 PERSONAS ESTÁN HOSPITALIZADAS

ENTRE VARIOS AGENTES, SACARON LA ROPA Y RECUPERARON EL DINERO

LAS PEQUEÑAS SE ENCONTRABAN JUNTO A SU MADRE Y SU ABUELO, TAMBIÉN RESCATADOS

LAS PEQUEÑAS SE ENCONTRABAN JUNTO A SU MADRE Y SU ABUELO, TAMBIÉN RESCATADOS
DIEZ PERSONAS PERMANECEN HOSPITALIZADAS

COSTÓ 450 MILLONES